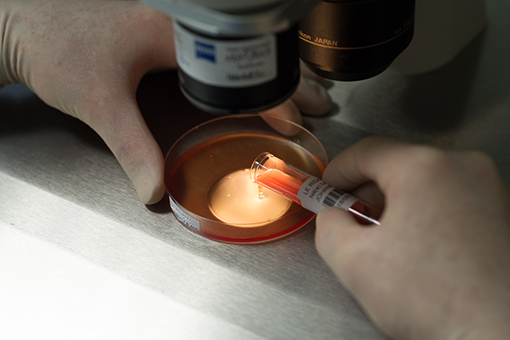

PMA et biologie de la reproduction
Ce reportage au service de biologie de la reproduction CECOS (Centre d'Etude et de Conservation des Ovocytes et du Sperme Humain) de l'hôpital l'Archet de Nice est un voyage au coeur de la fabrication de la vie. C’est ici qu’on cultive les embryons, qu’on analyse le sperme et qu’on le prépare pour les FIV, qu’on réalise des ponctions folliculaires par voie vaginale, qu’on diagnostique les ovocytes puis qu’on les stocke en incubateur en attendant de les féconder, qu’on injecte un spermatozoïde dans l’ovocyte pour réaliser une fécondation in vitro, qu’on dépose des embryons dans l’uterus de femmes infertiles, qu’on vitrifie les embryons dans l’azote liquide.